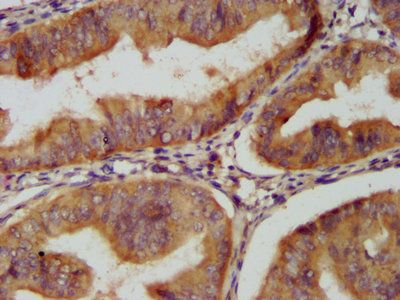
CLU Antibody

You have no items in your shopping cart.
CLU Antibody
Description
Research Area
Images & Validation
−| Tested Applications | IHC, WB |
|---|---|
| Reactivity | Human |
Key Properties
−| Host | Mouse |
|---|---|
| Clonality | Monoclonal |
| Isotype | IgG2b |
| Clone No. | CLU/4723 |
| Immunogen | Recombinant fragment (around aa150-300) of human CLU protein (exact sequence is proprietary) |
| Target | CLU |
| Source/Expression System | Bioreactor |
| Molecular Weight | 70kDa (precursor); 36-39kDa (√§¬º¬); 34-36kDa (√•¬∞¬æ) |
| Purification | Protein A |
| Conjugation | Unconjugated |
Storage & Handling
−| Storage | Maintain refrigerated at 2-8°C for up to 2 weeks. For long term storage store at -20°C in small aliquots to prevent freeze-thaw cycles. |
|---|---|
| Form/Appearance | 200ug/ml of Ab purified from Bioreactor Concentrate by Protein A/G. Prepared in 10mM PBS with 0.05% rAlbumin & 0.05% azide. Also available WITHOUT rAlbumin & azide at 1.0mg/ml. |
| Disclaimer | For research use only |
Alternative Names
−Similar Products
−CLU Antibody (N-term) [orb1938586]
FC, IHC-P, WB
Human, Mouse, Rat
Rabbit
Polyclonal
Unconjugated
100 μl, 50 μlClusterin rabbit pAb Antibody [orb764881]
ELISA, IF, IHC, WB
Human, Mouse, Rat
Polyclonal
Unconjugated
100 μlCLU Antibody [orb1410386]
IHC, WB
Human
Mouse
Monoclonal
Unconjugated
20 μg, 100 μg, 100 μg (without BSA and Azide)

Quality Guarantee
Explore bioreagents carefree to elevate your research. All our products are rigorously tested for performance. If a product does not perform as described on its datasheet, our scientific support team will provide expert troubleshooting, a prompt replacement, or a refund. For full details, please see our Terms & Conditions and Buying Guide. Contact us at support@biorbyt.com.

Analysis of Protein Array containing more than 19000 full-length human proteins using Clusterin / APOJ Mouse Monoclonal Antibody (CLU/4723). Z- and S- Score: The Z-score represents the strength of a signal that a monoclonal antibody (MAb) (in combination with a fluorescently-tagged anti-IgG secondary antibody) produces when binding to a particular protein on the HuProtTM array. Z-scores are described in units of standard deviations (SD's) above the mean value of all signals generated on that array. If targets on HuProtTM are arranged in descending order of the Z-score, the S-score is the difference (also in units of SD's) between the Z-score. S-score therefore represents the relative target specificity of a MAb to its intended target. A MAb is considered to specific to its intended target, if the MAb has an S-score of at least 2.5. For example, if a MAb binds to protein X with a Z-score of 43 and to protein Y with a Z-score of 14, then the S-score for the binding of that MAb to protein X is equal to 29.

Formalin-fixed, paraffin-embedded human adrenal gland stained with Clusterin / APOJ Mouse Monoclonal Antibody (CLU/4723).

SDS-PAGE Analysis of Purified Clusterin / APOJ Mouse Monoclonal Antibody (CLU/4723). Confirmation of Purity and Integrity of Antibody.

Western Blot Analysis of human testis lysate using Clusterin / APOJ Mouse Monoclonal Antibody (CLU/4723).
Quick Database Links
UniProt Details
−Documents Download
Request a Document
Protocol Information
CLU Antibody (orb1410387)
Participating in our Biorbyt product reviews program enables you to support fellow scientists by sharing your firsthand experience with our products.
Login to Submit a Review